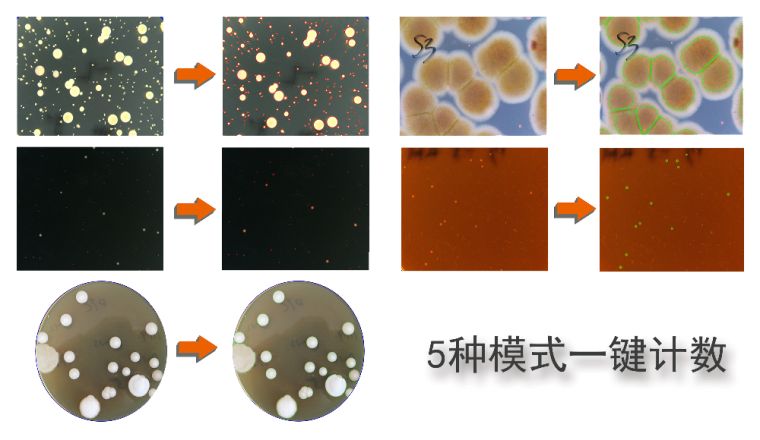

ZX系列全自动菌落分析仪,由图像采集系统和菌落统计分析软件构成,具有菌落统计、典型菌筛选、菌株特征检测与描述等功能,适用于生物医药、检验检疫、疾病控制、质量监督、环境监测、食品卫生,以及大专院校、研究院所等领域中的微生物菌落分析和科学研究
功能介绍
5模式一键计数

快速菌落统计:
分散菌统计:对边缘清晰,分散的菌落进行快速统计。
黏连菌统计:适用于背景颜色单一、菌落颜色不一致且边缘模糊的菌落快速统计。
与背景色相似菌统计:区域内菌落与培养皿背景颜色相似时,采用背景色相似菌统计。
微小菌统计:适应于微小菌落的统计。特大菌统计:区域内大菌落的快速统计,该算法偏重于大菌落统计。
数据安全与管理

1) 多用户登录系统,每个账户形成独立数据,数据**保存
2) 统计结果以PDF格式输出,原始数据不可更改
3) 具备审计追踪功能,操作人员在软件上的每一步操作软件自动记录,以便后续结果数据的追溯
4) 与CFR 21 第11部分兼容:系统安全,操作控制,文件管理
主要性能指标
1、成像装置
全封闭暗箱,能够消除外环境杂散光干扰
三色LED可见光
上、下光源亮度、开启关闭可自由切换,采用全触摸式调节按钮
色温自动控制,接近自然光
500万像素标清彩色相机
200万像素高清镜头 8mm
2、软件功能
1)分类一键统计:
背景相近菌一键计数
微小菌一键计数
分散菌一键计数
粘连菌一键计数
大菌落一键计数
2)辅助统计工具:
人工修正:鼠标单击可添加或删除遗漏菌落
智能修正:在一键统计基础上可进行智能修正
样本菌落总数换算:根据实际培养皿直径、样本稀释度,实现自动换算
3)数据安全与管理:
多用户登录系统,每个账户形成独立数据,数据长久保存
统计结果以PDF格式输出,原始数据不可更改
具备审计追踪功能,操作人员在软件上的每一步操作软件自动记录,以便后续结果数据的追溯
与CFR 21 第11部分兼容:系统安全,操作控制,文件管理
配置
ZX-100型自动菌落计数仪主机
Zstream自动菌落分析软件
商务台式电脑